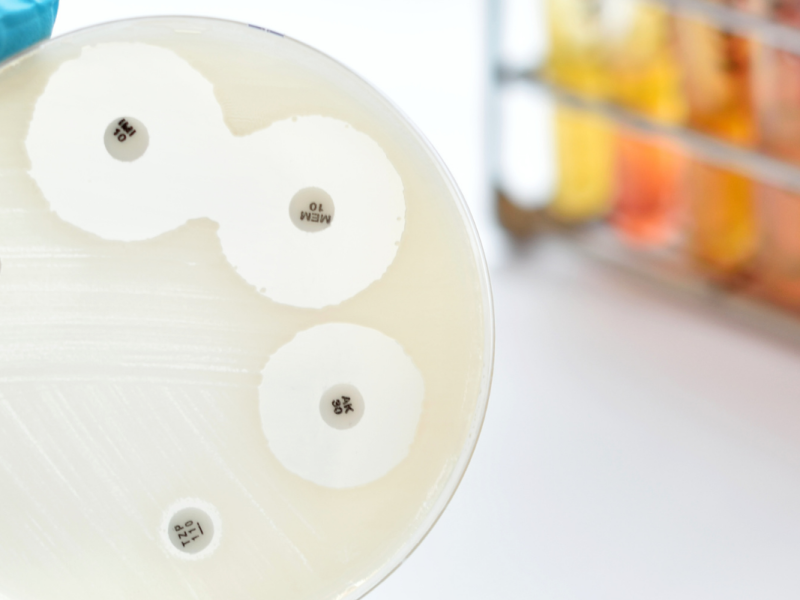

150 eventos
-

The spring edition of the BIPs is here! Choose among 25 Blended Intensive Programs and apply by April 28th!
18 mar. → 28 abr. 2024closed
-

New Psychoactive Substances: Clinical-Biological aspects
10 abr. 2024closed
-

Registrations are open for CIVIS BIPs! Apply by February 25
5 → 25 feb. 2024closed
-

RIS4CIVIS Innovation and Start-up Training Programme
17 nov. 2023 → 23 feb. 2024closed
-

Birds in our campuses - Winter edition
22 ene. → 10 feb. 2024closed
-

PolyCIVIS conference: Confronting the Polycrisis in Europe and Africa
30 ene. → 2 feb. 2024 -

British Bisexual Men & Their Intimate Partners: Identities, Relationships & Prejudice
13 dic. 2023closed
-

Cross-Alliances Forum 2023: Science with and for society in European Universities alliances
30 nov. → 1 dic. 2023 -

RIS4CIVIS final conference
29 nov. 2023closed
-

Sapienza training offer on soft skills for Early Stage Researchers
7 nov. 2023closed
-

Biomedical Imaging School 2023
29 oct. → 4 nov. 2023 -

Making Visible the Invisibles Research on Inequalities and Injustices in Cities
27 → 29 sep. 2023closed
-

Webinar: Discover Radiotheranostics in Nuclear Medicine
21 → 22 sep. 2023closed
-

CIVIS gender studies lectures: Women in American Studies - History of a discipline from a gender perspective
21 jun. 2023closed
-

Marie-Sklodowska Curie Actions online infoday
12 jun. 2023closed
-

CIVIS gender studies lectures: Female genital mutilation or modification? The socio-legal conundrums of the international zero-tolerance approach
17 may. 2023closed
-

Webinar series: Challenges and solutions to ageing in place
14 feb. → 16 may. 2023closed
-

CIVIS gender studies lectures: Growing up Queer in contemporary Greece - Tactics of everyday life
26 abr. 2023closed
-

New psychoactive substances: Clinical-biological aspects
21 → 22 mar. 2023closed
-

CIVIS gender studies lectures: Dealing with disrespect - How women attribute experiences of unequal treatment
15 mar. 2023closed
-

Functional Neuroanatomy: an overview of the main brain systems
24 feb. → 10 mar. 2023closed
-

Interdisciplinary Approaches to Scientific Research 2023
31 ene. → 7 mar. 2023closed
-

CIVIS gender studies lectures: The Female turn - How evolutionary science shifted perceptions about females
15 feb. 2023closed
-

Meet the newest CIVIS3i research fellows!
27 ene. 2023closed
-

Info Session: Micro-Programme on Global Awareness
24 oct. 2022 -

Aix-Marseille Erasmus Days Online Language Cafe
13 oct. 2022closed
-

Webinar on wellbeing and mental health at the work place
10 oct. 2022closed
-

2022 CIVIS CHANCE Romania Workshop
19 → 23 sep. 2022 -

Building the CIVIS Geochronology Network (CGN)
15 → 16 sep. 2022closed
-

Webinar: Discover Radiotheranostics in Nuclear Medicine
15 → 16 sep. 2022closed
-

InfoDay for CIVIS3i second call applicants
16 sep. 2022closed
-

Post-racial transmodernities: Afro-European relations, Mediterranean trajectories & intercultural reciprocities
8 sep. 2022closed
-

Legacies and memories of the past
1 → 2 sep. 2022closed
-

War. Flight. Migration - Ukrainian experiences and perspectives
21 jul. 2022closed
-

Theatre of Migration Festival
12 → 14 jul. 2022closed
-

CIVIS transnational initiative: How can universities support migrants and refugee communities?
13 jul. 2022closed
-

Treat a tooth or place an implant: diagnosis, decision, and planning
8 jul. 2022closed
-

Webinar: Diabetic cardiomyopathy
8 jul. 2022closed
-

Vital pulp therapy and regenerative Endodontics: two parallel paths?
6 jul. 2022closed
-

CIVIS webinar series: Challenges and solutions to ageing in place
10 feb. → 30 jun. 2022closed
-

CIVIS webinar series & Summer School: "The patient-doctor relationship in the digital era"
27 ene. → 22 jun. 2022closed
-

NaturaShare: Launch of the Citizen Data Collection Week
17 jun. 2022closed
-

UAM Local CIVIS Days: Open Lab, the link between the university and its environment
17 jun. 2022closed
-

Conference: How to engage with the Mission “Restore our Ocean and Waters by 2030”
13 → 14 jun. 2022closed
-

CBCT in endodontics
13 jun. 2022closed
-
Webinar: Current progress in the development of novel antimicrobials
7 → 8 jun. 2022closed
-

Webinar: Medication related osteonecrosis of the jaw (MRONJ)
6 jun. 2022closed
-

Second Neuroscience Symposium Aix-Marseille - Tübingen
3 jun. 2022closed
-

Webinar: Non-plaque induced gingival diseases (oral medecine)
30 may. 2022closed
-

Design of European degrees – Building flexible pathways beyond academic cycles
26 → 27 may. 2022closed